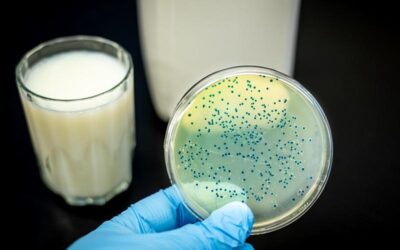
Jakie bakterie znajdują się w mleku?

Charm Test to rewolucyjne narzędzie, które może znacząco wpłynąć na jakość i bezpieczeństwo produktów mleczarskich oraz obniżyć koszty operacyjne w branży. Czym dokładnie jest i w jakich przypadkach znajduje zastosowanie? Na te pytania odpowiadamy w niniejszym wpisie....
Newsy
Jak zadbać o czystość wody?
Woda to jeden z najważniejszych zasobów na naszej planecie. Jej czystość ma kluczowe znaczenie dla prawidłowego funkcjonowania organizmu, dlatego warto wiedzieć, jak zadbać o jej jakość oraz jakie testy można wykonać, aby upewnić się, co można znaleźć w jej składzie....
Jak sprawdzić czy w mleku są antybiotyki?
Mleko to podstawowy produkt spożywczy, który dostarcza organizmowi niezbędnych składników odżywczych, takich jak białko, witaminy i minerały. Okazuje się jednak, że mimo bogactwa kluczowych dla zdrowia składników, w jego składzie mogą znaleźć się też substancje...
Czym są i czemu służą testy ATP?
Testy ATP to szybki sposób na ocenę czystości badanego materiału. Wykorzystuje się je w wielu branżach, w tym np. w przetwórstwie mleczarskim. Co warto wiedzieć o takich badaniach? W niniejszym artykule przyjrzymy się ich przebiegowi oraz szerokim zastosowaniom. Testy...
Wykrywanie pozostałości antybiotyków w mleku
Przez wieki mleko stanowiło cenione źródło ważnych składników odżywczych. Zapewnienie jego bezpieczeństwa jest niezwykle istotne. Pozostałości antybiotyków w mleku mogą przyczyniać się do rozwijania oporności bakterii chorobotwórczych na antybiotyki oraz...
Czemu służą i jak działają szczepionki mleczarskie?
Sery, twarogi, jogurty, kefiry – te produkty goszczą często na wielu stołach każdego dnia. Jednak aby powstały konieczne jest zastosowanie odpowiednich szczepionek mleczarskich, które pozwolą na uzyskanie z mleka krowiego końcowego produktu o odpowiedniej...
Jak działa inkubator do mleka?
Producenci mleka i przetworów mlecznych muszą m.in. przestrzegać wielu parametrów hodowli i kontrolować jakość swoich produktów. Inkubator do mleka, będący jednym z najważniejszych urządzeń w przemyśle mleczarskim, pozwala na sprawdzenie, czy surowiec spełnia...
Jakich rodzajów kultur bakterii używa się do produkcji kefirów i jogurtów?
Kefir i jogurt cieszą się popularnością od wielu lat. Warto je spożywać z uwagi na wiele korzyści zdrowotnych. Są one produkowane w procesie fermentacji, z wykorzystaniem wyselekcjonowanych bakterii. Poszczególne ich kultury mogą się różnić w zależności od rodzaju...
Na czym polega działanie szczepionek do sera?
Sery stanowią ważny element codziennej diety. W sklepach dostępne są ich różnorodne rodzaje, które cechują się odmiennym smakiem, kolorem i konsystencją. Występujące tu różnice wynikają z odmiennych procesów wytwórczych, a także stosowania wyselekcjonowanych bakterii...
Jak powstaje ricotta?
Ricotta to miękki, delikatny w smaku ser, który swoją historię powstania wywodzi z Włoch. Zgodnie z prawnymi przepisami ricotta, powszechnie nazywana serem, serem wcale nie jest. Jest ona produktem pochodnym z serwatki, z której powstaje podczas produkcji różnych...
Jakie probiotyki dodaje się do mleka?
O cennych właściwościach mleka nie trzeba zbyt wiele mówić. Chyba każdy wie, jak wiele dostarcza wartości odżywczych. Zdaje się, że szczególną rolę odgrywają probiotyki. Czym są probiotyki? Najprościej mówiąc, probiotyki to żywe kultury bakterii, które mają korzystny...
Jak nakłada się powłoki serowarskie?
Wyrabianie serów to stosunkowo pracochłonny proces, który wymaga nie lada wiedzy i doświadczenia. Każdy z etapów przygotowywania tego produktu ma bowiem bezpośredni wpływ na jego finalną jakość oraz smak. Ważne są nawet takie czynniki jak temperatura czy wilgotność....
Jakie zadania spełniają powłoki serowarskie?
Sery to jedne z ulubionych produktów Polaków. Na rynku dostępnych jest tak wiele ich rodzajów, że każdy możne z łatwością znaleźć swój ulubiony. Zanim jednak będzie można je nabyć, muszą one przejść przez proces produkcji. Zupełnie niezbędnym elementem w tym...
Na czym polega i do czego służy Charm Test?
Wprowadzanie mleka na rynek to dość skomplikowany proces. Musi być ono bowiem odpowiednio przebadane, a także spełniać szereg wymogów nakładanych przez prawo. Zupełną podstawą okazuje się jednak diagnostyka wszelkich wyrobów mleczarskich. Mowa tu między innymi o...
Jakie parametry spełnia zdrowe mleko?
Większość z nas nie wyobraża sobie codziennej diety bez mleka. Lubimy pijać je samodzielnie, a także przygotowywać różnorodne posiłki, których jest niezbędnym składnikiem. Niewiele osób bierze jednak pod uwagę to, po jaki produkt w ogóle sięga. Czy wiesz, jakie...
Jakie testy są stosowane do wczesnego wykrycia zakażenia mleka UHT?
Odzwierzęce produkty spożywcze wprowadzane na rynek muszą spełniać wszelkie wymogi bezpieczeństwa. Obowiązek ten dotyczy zarówno drobnych zakładów, lokalnych rolników, jak i dużych przedsiębiorstw. Mimo że mleko UHT podlega charakterystycznej dla niego sterylizacji,...
Jakimi testami określa się ogólną ilość bakterii w mleku?
Aby mleko było bezpieczne i zdrowe, musi mieć odpowiednią jakość higieniczną. Jego skład chemiczny, właściwości fizykochemiczne oraz ilość bakterii, które się w nim znajdują, decydują o technologicznej przydatności tego produktu. Co wpływa na jakość mleka?...
Kiedy stosuje się PEEL PLATE TEST i co wykazuje?
Aby mleko zostało dopuszczone do sprzedaży, musi spełniać szereg norm jakościowych. Dla konsumentów znaczenie ma przede wszystkim smak produktu i jego trwałość. Hodowcy bydła i producenci przetworów mlecznych, doskonale zdają sobie sprawę z tego, jak istotne znaczenie...
W jaki sposób zachowuje się czystość powietrza w zakładach przetwórstwa mleka?
Nabiał, a szczególnie zaliczane do tej kategorii mleko, jest ważnym produktem w diecie niemal każdego z nas. Niewiele osób wie jednak, że przygotowanie tego rodzaju propozycji wiąże się z dużymi wysiłkami podejmowanymi przez producentów. Jednym z najważniejszych...
Jak przeprowadzić badanie na czystość powierzchni?
W zakładach przetwórstwa mleka i tworzenia nabiału zasady higieny powinny przybierać naprawdę rygorystyczną formę. Tym bardziej że szkodliwe drobnoustroje mogą znajdować się na niemal każdej powierzchni, stanowiąc zagrożenie dla jakości całych partii produktu, a co za...
Jakie produkty bada się systemem EPIC?
Analityka mleka to ważny dział, który obejmuje szereg badań pozwalających określić skład mleka i weryfikujących jego przydatność do spożycia. Przeprowadzane badania pozwalają stwierdzić m.in. procentową zawartości tłuszczu, białka, laktozy, suchej masy, czy wody...
Do czego służy luminometr?
Produkcja żywności to bardzo szeroka dziedzina, w której ogromne znaczenie mają wysokie standardy jakości. Czynniki te wpływają zarówno na klasę finalnego produktu, ale także na bezpieczeństwo konsumentów jak i postrzeganie przez nich danej marki. Duże znaczenie ma...
Jakie zastosowanie mają testy ATP w przemyśle nabiałowym?
Prowadzenie przetwórstwa nabiałowego wymaga zachowania bardzo wysokich standardów bezpieczeństwa i higieny. Znaczenie takiej dbałości podkreślają m.in. specjalistyczne raporty, które donoszą, że każdego roku odnotowywane są liczne przypadki zatruć, wywołanych przez...
Jak należy przechowywać testy ATP?
Działalność związana z przetwórstwem mlecznym i tworzeniem produktów z kategorii nabiału wymaga zachowania wysokich standardów higieny. Praktyka pokazuje, że nawet najmniejsza ilość zanieczyszczeń może bowiem powodować skażenie nie tylko części surowca, ale nawet...
Jakich testów używa się do wykrycia antybiotyków w mleku?
Mleko, które spożywamy, a co za tym idzie także nabiał, powinny być produktami najwyższej jakości, które są zdrowe i wspierają funkcjonowanie naszego organizmu. Aby tak było bardzo ważne jest badanie tego typu propozycji m.in. pod kątem występowania antybiotyków i ich...
Etapy dojrzewania sera
Do przeprowadzenia procesu dojrzewania serów potrzebna jest stabilna temperatura otoczenia, zazwyczaj między 12 i 14 ⁰C. Z wyjątkiem serów typu szwajcarskiego, których dojrzewanie na pewnym etapie wymaga temperatury około 20 ⁰C. Istotnym elementem przygotowania...
Po czym poznać jakość sera?
Na rynku dostępne są sery w wielu gatunkach, kolorach i postaciach oraz tak zwane wyroby seropodobne, imitujące ser. Wiele osób ma nadal trudność z rozpoznaniem istotnej różnicy. Na pewno będą to rozbieżności w smaku i cenie. Co jeszcze warto wiedzieć, aby móc poznać...
Jak przebiega luminometryczne badanie mleka UHT?
W celu uniknięcia strat oraz zaoszczędzenia nakładów przemysł mleczarski wykorzystuje tak zwane czujniki biologiczne. Przykładem takiej procedury jest poddanie badaniu luminometrycznemu mleka surowego, będącego po obróbce cieplnej lub w trakcie przechowywania, co...
Czy w mleku występują konserwanty?
Proces technologiczny, w wyniku którego uzyskiwane jest tak zwane mleko spożywcze, składa się z kilku etapów. Wiele osób nurtuje dziś kwestia konserwowanej żywności oraz napojów. Jak to wygląda w przypadku produkcji mleka na skalę przemysłową? Zapraszamy do lektury...
Zastosowanie inkubatorów do mleka
Nasza firma TomLab Food Specialist specjalizuje się w zaopatrywaniu się laboratoriów w innowacyjne testy do badania mleka, które są szeroko wykorzystywane w branży mleczarskiej i szeroko zakrojonej branży rolniczej. Jednym z produktów cieszących się największą...
Jakie kultury bakterii znajdują się w twarogach?
Twarogi to bardzo popularne produkty spożywcze przetwórstwa mleczarskiego. Tradycyjne twarogi można z łatwością przygotować, ukwaszając mleko, wykorzystuje się wówczas bakterie obecne w mleku lub można skorzystać z rozwiązania dającego bardziej przewidywalne efekty w...
Rodzaje szczepionek mleczarskich
Niegdyś zaszczepy do wytwarzania produktów mleczarskich były wytwarzane domowymi sposobami. Wówczas wykorzystywane bakterie natywne, które są składniekiem mleka krowiego. Obecnie, kiedy mamy do czynienia z prężnym rozwojem przemysłu mleczarskiego, za wytworzenie...
Czym są luminometry?
Luminometria była swego czasu wykorzystywana przez NASA do wykrywania nowych form życia na innych planetach. Aktualnie wykorzystywana jest w wielu branżach przemysłowych jako podstawa działania czujników biologicznych. Powstające w przemyśle spożywczym różnego rodzaju...
Jak dobrostan krów wpływa na jakość mleka?
Na poprawne rozumienie pojęcia dobrostanu składają się trzy elementy. Pierwszym z nich naturalne, czyli zgodne z biologią danego zwierzęcia funkcjonowanie, drugim elementem są emocje, których zwierzę doświadcza, zaś trzecim zdolność zwierzęcia do wyrażania naturalnego...
Produkcja ricotty krok po kroku
Ricotta to miękki, delikatny w smaku ser, który swoją historię powstania wywodzi z Włoch. Zgodnie z prawnymi przepisami ricotta, powszechnie nazywana serem, serem wcale nie jest. Jest ona produktem pochodnym z serwatki,...
Metody pakowania sera
Wyjątkowe walory smakowe serów oraz możliwość ich szerokiego zastosowania w sztuce kulinarnej sprawiły, że sery na stałe zagościły na naszych stołach. Trudno określić dokładną datę rozpoczęcia produkcji serów, jednak miało to miejsce niedługo po udomowieniu bydła. Od...
Najważniejsze składniki mleka
Na temat mleka istnieje wiele mitów. Jedni naukowcy twierdzą, że mleko należy spożywać codziennie, inni, że dorosłym ono nie służy. Czym się kierować szukając odpowiedzi, co jest prawdą, a co nią nie jest? Warto uwzględnić najnowszą piramidę żywienia powstałą z...
Na czym polega charm MRL Test?
Nasza firma tomlab.pl specjalizuje się w zakresie szeroko pojętej analityki mleka, która ma na celu analizę składu mleka. Na podstawie analizy składu mleka określa się jego przydatność do spożycia, zawartość procentową poszczególnych składników niezbędnych dla...
Szczepionki do sera. Przegląd rozwiązań
Sery są jednym z tych elementów naszej diety, dlatego pojawiają się na naszych talerzach niemal codziennie. W sklepach możemy przebierać w różnych rodzajach serów żółtych, które różnią się między sobą smakiem, aromatem, a także konsystencją. Każdy znajdzie dla siebie...
Jak powstaje mascarpone?
Mascarpone jest obecnie jednym z najpopularniejszych serów wykorzystywanych do pieczenia ciast i tworzenia deserów z delikatną, śmietankową masą. Popularność zyskał dzięki niezwykle łagodnemu i słodkiemu smakowi. Najbardziej znany w Polsce jest jako główny składnik...
Na czym polega bioprotekcja mleka?
Wszyscy zdajemy sobie doskonale sprawę z tego, jak ważne jest dla naszego zdrowia jedzenie produktów spożywczych zawierających w sobie cenne witaminy i mikroelementy. To dlatego do naszej codziennej diety należy włączać produkty mlekopochodne, które są bogatym źródłem...
Jakie kultury bakterii znajdują się w jogurtach i kefirach?
Jogurt i kefir to napoje, które powstają z mleka, a ich regularne picie sprawia, że dostarczamy naszemu organizmowi odpowiednią ilość wapnia, a także dobroczynną florę bakteryjną, która jest odpowiedzialna za prawidłowe funkcjonowanie naszego układu trawiennego,...
Jak powstaje słodki twaróg?
Twaróg nazywany też białym serem jest w naszym kraju bardzo popularnym produktem wytwarzanym z mleka. Jego historia jest długa, bo wyrabiano go jeszcze w czasach starożytnych, a w Polsce jest znany od wielu stuleci. Obecnie nasz kraj jest jednym z większych...
Jak dbać o czystość powietrza w zakładach przetwórstwa mlecznego?
Zanieczyszczone powierzchnie mogą mieć negatywny wpływ na produkowane w danym zakładzie przetwory mleczne, a w skrajnych przypadkach skutkować wysokimi karami dla zakładu lub nawet jego zamknięciem. Dlatego poza restrykcyjnymi przepisami prawa w życie wszedł także...
Testy ATP do mleka. Charakterystyka
Mleko dostarczane przez właścicieli krów do zakładów mleczarskich nie może być skażone mikroorganizmami szkodliwymi dla człowieka. Aby wykryć ich obecność, przeprowadza się specjalne testy do mleka. Przykładem takiego testu jest nasz produkt – PocketSwab Plus. Jak on...
Jak testuje się czystość mleka?
Bakterie dostają się do mleka z kanałów strzykowych wymienia i ze środowiska zewnętrznego. To drugie obejmuje m.in. zły stan skóry krowy, brudne urządzenia używane do doju, nieprzestrzeganie zasad higieny przez personel, złe jakościowo powietrze w oborze oraz pasze. W...
Zakażenie mleka. Możliwe zagrożenia
Mleko uznawane jest za produkt zdrowy i bezpieczny do spożycia, jednak tylko wtedy, gdy produkujący je zakład przestrzega ścisłych norm jakościowych i dba o zachowanie higieny procesu wytwórczego. W tym celu stosowane są nowoczesne technologie analityczne, które...
Dlaczego mleko jest zdrowe?
Mleko krów towarzyszy ludzkości od 11 tysięcy lat i po dzień dzisiejszy jest bardzo chętnie spożywanym produktem. Nic dziwnego. Znajduje się w nim skarbnica cennych witamin i minerałów, które dla zachowania zdrowia, powinny znaleźć się w codziennej diecie człowieka....
Jak dbać o czystość mleka?
Mleko to życiodajny napój, który odgrywa bardzo ważną rolę w codziennej diecie człowieka, a zwłaszcza w pierwszym okresie życia pozapłodowego. Skład bogaty w białko, wapń, potas, magnez i wiele innych minerałów oraz witamin wpływających korzystnie na nasze zdrowie...
Jakie bakterie znajdują się w mleku?
Produkty na bazie mleka często zalecane są osobom, które przeszły kurację antybiotykową wyjaławiającą florę bakteryjną jelit. Nic dziwnego. Mleko i jego przetwory to źródła mikroorganizmów mających pozytywny wpływ na jej odbudowę, choć bez rzetelnych kontroli...
Witamy na blogu firmy Tomlab
Blog firmy Tomlab. Witamy na naszym blogu. Stworzyliśmy go po to, żeby zaprezentować i przybliżyć ofertę naszej firmy. Znajdziesz tu wiele przydatnych informacji dotyczących naszej branży oraz materiałów pomagających w dokonaniu wyboru właściwych elementów...
Zalety i wady mleka UHT
Mleko od lat uważane jest za bogaty w białko produkt, którego regularne spożywanie niezwykle korzystnie wpływa na nasz organizm. Najbardziej cenione jest mleko, w które zaopatrujemy się u lokalnych dostawców, gdyż mamy pewność, że jest świeże i pełne zdrowych...
Druga część filmu reklamowego
Dzięki licznym badaniom prowadzonym przez ponad 20 lat, firma SCA jest liderem w dziedzinie technologii mascarpone (szczególnie w etapie krzepnięcia- koagulacji). Delikatna i kompletna koagulacja wszystkich rodzajów białek osiągnięta zostaje dzięki odpowiedniemu...
Natura przeciw konserwantom
Ponad 35 letnie doświadczenie firmy Domca zainspirowało nas do opracowania innowacyjnych procesów technologicznych dostosowanych do potrzeb Kliena. Skoncentrowaliśmy się na opracowaniu produktów na bazie naturalnych składników charakteryzujących się niską zawartością...
Peel Plate EC
Peel Plate EC (E.coli oraz Coliformy) test, wykorzystuje tradycyjne EC podłoża z barwną produkcją enzymatycznych substratów oraz 24 godzinną inkubacją. Coliformy wytwarzają łatwe do interpretacji czerwone kolonie i nie wymagają dodatkowych czynności potwierdzających....
Peel Plate AC
Peel Plate AC służy do wykrywania i oznaczania liczby bakterii tlenowych w mleczarstwie, produktach spożywczych oraz próbkach wody. Próbka lub ekstrakt próbki naniesiony jest i inkubowany przez 48 godzin w 32°C dla produktów mlecznych i 35°C dla innych produktów. Peel...
EPIC System
System EPIC jest mikropłytkowym bioluminescencyjnym systemem, który wykrywa zakażenie bakteriami przetrwalnikującymi w produktach pitnych UHT oraz ESL. EPIC wykrywa ATP, który jest bio-markerem mówiącym o zakażeniu mikrobiologicznym. EPIC jest w stanie wykryć...
novaLUM II System
NOWOŚĆ - nowej generacji luminometr novaLUM II novaLUM II System Zaawansowana czułość: novaLUM II ATP System Detekcji - urządzenie powstałe na platformie palmtopa połączonego z luminometrem, dzieło naukowców, oferujące monitoring czystości na najwyższym poziomie. W...